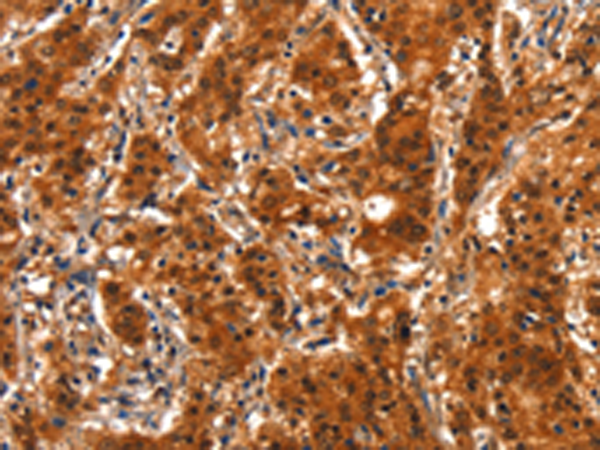
一抗

|
Background: |
E3 ubiquitin-protein ligase SMURF2 is an enzyme that in humans is encoded by the SMURF2 gene. E3 ubiquitin-protein ligase which accepts ubiquitin from an E2 ubiquitin-conjugating enzyme in the form of a thioester and then directly transfers the ubiquitin to targeted substrates. Interacts with SMAD1 and SMAD7 in order to trigger their ubiquitination and proteasome-dependent degradation. In addition, interaction with SMAD7 activates autocatalytic degradation, which is prevented by interaction with SCYE1. Forms a stable complex with the TGF-beta receptor-mediated phosphorylated SMAD2 and SMAD3. |
|
Applications: |
ELISA, IHC |
|
Name of antibody: |
SMURF2 |
|
Immunogen: |
Synthetic peptide of human SMURF2 |
|
Full name: |
SMAD specific E3 ubiquitin protein ligase 2 |
|
SwissProt: |
Q9HAU4 |
|
IHC positive control: |
Human gastric cancer and human liver cancer |
|
IHC Recommend dilution: |
25-100 |

 購(gòu)物車
購(gòu)物車 幫助
幫助
 021-54845833/15800441009
021-54845833/15800441009